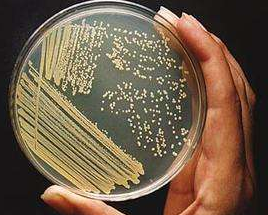
图片9.png 图片9.png

High Nucleic acid Yeast Extract
Product Introduction:
High nucleic acid yeast extract (abbreviated as YE) is a natural umami flavor enhancer prepared ingredient. It is fermented with high-quality molasses and starch sugars as raw materials, using modern biotechnology, by enzymatic hydrolysis of proteins and nucleic acids in yeast cells, then separation, and concentration, get the pure natural highly nutritious product. The main components are polypeptide, amino acid, ribonucleic acid, vitamin and trace elements. It is also an ideal biological culture medium and the raw material for fermentation industry.
Raw material:
Food yeast, sugar cane molasses, starch sugar, etc.

Product features

n Key technology won the second prize of 2015 National Technology Invention Award
n Pure natural products, no external source added, high water solubility
n Self-selection high nucleic acid yeast species (18%) and nuclease P1 Penicillium citrinum.
n Continuous fermentation, efficiency increase 300%, sewage discharge reduce 70%.
n Products through ISO9001, HACCP, Kosher, Halal, GMP+





Nutritional Components
High-nucleic acid yeast extract is rich in ribonucleic acid, amino acids, peptides, various vitamins, and trace elements. Nucleic acid is an important genetic material basis for the growth and reproduction of microorganisms. It can provide microorganisms with the nucleic acid raw materials needed for synthesizing their own genetic material and proteins, which helps accelerate the growth and reproduction of microorganisms. For example, in the cultivation of Escherichia coli or cytidine, it can significantly increase their reproduction rate and the yield of metabolic products. Abundant amino acids are important raw materials for microorganisms to synthesize their own proteins, providing nitrogen and carbon sources for microbial growth and meeting their growth and metabolic needs. It is also rich in B vitamins and other vitamins, as well as trace elements such as iron, zinc, and magnesium, which participate in various metabolic reactions in microorganisms.
Product Functions:
n Accelerate Growth Rate: The nucleic acids, amino acids, and other nutritional components in high-nucleic acid yeast extract can provide comprehensive and easily absorbable nutrients for microorganisms, shorten the growth lag phase of microorganisms, enable them to enter the logarithmic growth phase faster, accelerate the growth rate, and improve fermentation efficiency. For example, in the fermentation production of guanosine monophosphate, using high-nucleic acid yeast extract as a medium component can make yeast reach the maximum growth rate faster and shorten the fermentation cycle.
n Improve Fermentation Product Yield: It provides favorable nutritional conditions for microbial growth, enabling microorganisms to carry out metabolic activities more fully, thereby increasing the yield and quality of fermentation products. In the fermentation production of antibiotics, amino acids, enzymes, etc., adding high-nucleic acid yeast extract can promote the growth of antibiotic-producing microorganisms such as actinomycetes, thereby increasing the yield of antibiotics.
n Enhance Microbial Vitality: It helps maintain the normal physiological functions and metabolic activity of microbial cells, enhances the resistance of microorganisms to environmental pressures such as temperature and pH changes, enables microorganisms to maintain high vitality during the fermentation process, and reduces growth stagnation or death caused by environmental changes.
n Improve the Flavor and Taste of the Medium: In media used for food fermentation, nucleic acids will produce various flavor nucleotides such as inosinic acid, guanosine monophosphate, and adenosine monophosphate during enzymatic hydrolysis, giving the medium a unique umami and mellow taste. Its unique flavor can improve the flavor and taste of fermented foods, making the products more competitive in the market. For example, in the production of soy sauce, vinegar, fermented beverages, etc., it can increase the umami and mellow taste of the products and improve product quality.
Product Advantages:
n Pure Natural Product: Adopting modern advanced biotechnology, it is refined from edible yeast through autolysis, enzymatic hydrolysis, and other processes. It is a pure natural nutrient without harmful chemicals, conforming to the modern green and environmental protection production concept, and can be safely used for the cultivation of various microorganisms.
n Stable and Reliable Quality: The production process is carried out in strict accordance with standardized procedures, with strict requirements for raw material selection, production process parameter control, product quality inspection, and other links. This ensures that the nutrient content of each batch of products is stable and the quality is consistent, providing a stable nutritional environment for microbial cultivation and ensuring the stability and repeatability of the fermentation process.
n Good Solubility and Compatibility: It has good solubility in water, can quickly dissolve in the medium, and uniformly provide nutrients for microorganisms. At the same time, it has good compatibility with other medium components, will not chemically react with other components or produce precipitation, and can be used in combination with various carbon sources, nitrogen sources, inorganic salts, etc., to meet the cultivation needs of different microorganisms.
Applications:
Food Fermentation Field
n Raw Material for Condiment Production: High nucleic acids will produce various flavor nucleotides during enzymatic hydrolysis, which is conducive to increasing flavor and nutrition. It is a natural high I+G extract and a high-quality raw material for the fermentation production of inosinic acid, guanosine monophosphate, etc.
n Soy Sauce Brewing: In the soy sauce brewing process, high-nucleic acid yeast extract can provide nutrients for microorganisms such as Aspergillus oryzae, promote their growth and metabolism, produce abundant enzymes, accelerate the decomposition of proteins and starches, improve the umami and flavor of soy sauce, and increase the content of nutrients such as amino acid nitrogen in soy sauce.
n Production of Fermented Dairy Products: Such as yogurt, cheese, etc., it helps the growth and reproduction of probiotics such as lactic acid bacteria, regulates the fermentation process, improves the taste and flavor of products, and increases the nutritional value of products.
Fermentation Industry and Microbial Cultivation Field
n Industrial Fermentation Medium: With rich amino acids and nucleic acid components, it is a raw material for the fermentation of inosinic acid, guanosine monophosphate, and high-end amino acids.
n Bacterial Cultivation: Such as the cultivation of Escherichia coli, Bacillus subtilis, etc. High-nucleic acid yeast extract can provide rich nitrogen sources, nucleic acids, and other nutrients, helping the rapid growth and reproduction of bacteria, improving yield and activity, and is often used in the production of antibiotics, enzymes, etc.
n Fungal Cultivation: It is also very important for the cultivation of fungi such as yeast and molds. For example, in the fermentation production of alcohol, beer, etc. by yeast, high-nucleic acid yeast extract can provide comprehensive nutrients for yeast cells, promote yeast fermentation, and improve fermentation efficiency and product quality; in mold cultivation, it is used to produce certain fungal polysaccharides, organic acids, etc.
Biopharmaceutical Field
n Vaccine Production: In vaccine production, it is used to cultivate microorganisms or cells for vaccine production. For example, in the production of influenza vaccines, when cultivating host cells relied on by influenza viruses, high-nucleic acid yeast extract can provide nutrients required for cell growth, support cell proliferation and virus reproduction, and ensure the yield and quality of vaccines.
n Production of Genetic Engineering Drugs: In the production of pharmaceutical proteins using genetically engineered bacteria, such as insulin, growth hormone, etc., high-nucleic acid yeast extract can meet the needs of rapid growth of engineered bacteria and efficient expression of target proteins, improving the expression level and activity of pharmaceutical proteins.

Products Specifications:
Item | YE300 (Powder) | YE301 (Powder/Paste) | YE311 (Powder/Paste) |
Appearance | Light yellow or yellowish-brown powder/ Brownish paste | ||
Nucleic acid | ≥12% | ≥16% | ≥22% |
Total nitrogen | ≥9% | ≥10% | ≥10% |
Amino acid nitrogen | ≥3% | ≥4% | ≥4% |
Moisture | ≤6%, | ≤6%,≤35% | ≤6%,≤35% |
Heavy metal | ≤20% | ≤20% | ≤20% |
Packing specification: Powder, 20kg/ bag/ barrel, or Paste, by ton bucket
Product Storage Proposal: Place in a cool, dry place to keep out moisture.
Shelf life: 18 months from the production date without opening.



